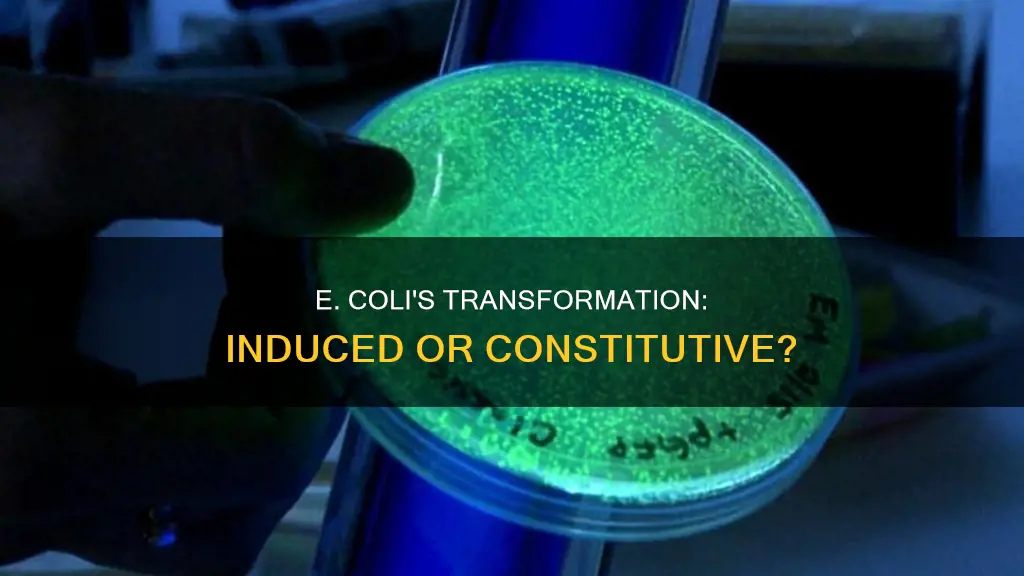
does e coli use constitutive or induced transformation

E. coli is the most common bacterial species used in the transformation step of a cloning workflow. The transformation of E. coli involves introducing foreign DNA using plasmid vectors or homologous recombination events. The transformation of E. coli can be achieved through chemical treatment or electroporation. The former uses chemical inducers such as calcium chloride to create an attraction between the DNA and the cell surface, while the latter uses electric fields to generate pores in the bacterial cell membrane. The choice between using constitutive or induced transformation in E. coli depends on the specific experimental goals and the desired expression timing and ratios of the genes involved.
| Characteristics | Values |
|---|---|
| E. coli transformation | Allows the introduction of heterologous DNA using plasmid vectors or introducing mutations via homologous recombination events |
| Bacterial transformation | A primary technique in molecular cloning to produce multiple copies of a recombinant DNA molecule |
| Transformation of bacteria with plasmids | Important for studies in bacteria and because bacteria are used to store and replicate plasmids |
| Transformation | The process by which foreign DNA is introduced into a cell |
| Transformation methods | Heat shock, electroporation, chemical transformation, calcium chloride transformation |
| Transformation efficiency | Commercial competent cells range significantly; higher efficiency cells are more important if working with very small amounts of DNA or multiple plasmids |
| Transformation of E. coli | Can be achieved through chemical treatment of cells or exposing the cells to electric pulses (electroporation) |
| Transformation of E. coli with calcium | Calcium-induced competence is achieved by incubating cells with divalent cations, particularly calcium (Ca2+), which neutralises the charge repulsion of DNA and enables its uptake |
| Transformation of E. coli with heat shock | Cells are subjected to a sudden increase and then decrease in temperature, causing the cell membrane to become more permeable and facilitating DNA uptake |
| Transformation of E. coli with multiple plasmids | E. coli bacteria readily accept multiple plasmids, resulting in widespread aclonality and complex colony development patterns |
| Transformation of E. coli with promoters | Both constitutive and inducible promoters can be used to express genes in E. coli; the choice depends on the experiment and the desired expression timing and ratios of the proteins |
Explore related products
$161.99
What You'll Learn
- E. coli transformation introduces heterologous DNA using plasmid vectors or homologous recombination
- E. coli is the most common species used in the transformation step of a cloning workflow
- Transformation of bacteria with plasmids is important for studies and as a means of storing and replicating plasmids
- Calcium-induced competence is a procedure that involves exposing cells to cations to induce chemical competence
- The easiest way to express three genes concurrently is to make an operon and use a single promoter

E. coli transformation introduces heterologous DNA using plasmid vectors or homologous recombination
E. coli transformation is a technique used in molecular cloning to introduce foreign DNA into bacterial cells, resulting in the acquisition of new genetic traits. This process can be achieved through the use of plasmid vectors or homologous recombination.
E. coli Transformation Using Plasmid Vectors
Plasmids are circular DNA molecules that can replicate independently of the bacterial chromosome. They are often used as vectors to transfer DNA between different organisms, such as bacteria and yeast. In the case of E. coli transformation, plasmids are used to introduce heterologous DNA into the bacteria. This process is known as bacterial transformation and is a routine laboratory procedure.
To prepare for E. coli transformation using plasmid vectors, recombinant plasmids are constructed by inserting the DNA sequence of interest into a vector. The competent E. coli cells are then transformed with the plasmid, allowing the bacteria to replicate the sequence of interest in amounts suitable for further analysis or manipulation.
E. coli Transformation Using Homologous Recombination
Homologous recombination is a process where DNA sequences are exchanged between similar or identical molecules of DNA. In the context of E. coli transformation, homologous recombination can be used to engineer the bacterial chromosome and bacterial plasmids in vivo. This technique, known as recombineering, allows for the insertion or deletion of DNA sequences without regard to the location of restriction sites.
Recombineering in E. coli can be achieved using PCR products, synthetic double-strand DNA (dsDNA), or single-strand DNA (ssDNA) as substrates. The recombineering process involves the use of bacteriophage-encoded recombination proteins that can efficiently recombine sequences with homologies as short as 35 to 50 bases. This technique can also be combined with CRISPR/Cas targeting systems for more precise genetic modifications.
Factors Affecting E. coli Transformation Efficiency
The efficiency of E. coli transformation can be influenced by various factors. The transformation efficiency of competent cells is typically measured by the uptake of plasmid DNA, and it can be increased by using specific treatments or generating "competent cells." Commercially available competent cells vary in their transformation efficiency, with higher efficiency cells being more important when working with very small amounts of DNA or multiple plasmids.
Additionally, the type of plasmid used can impact transformation efficiency. For example, circular plasmids are generally more efficient for transformation than linear plasmids. Furthermore, the preparation of cell extracts and the concentration of DNA can also play a role in the success of E. coli transformation.
The American Flag: Wear or Not to Wear?
You may want to see also
Explore related products

E. coli is the most common species used in the transformation step of a cloning workflow
Bacterial transformation is a primary technique in molecular cloning to produce multiple copies of a recombinant DNA molecule. It is a process in which foreign DNA is introduced into bacterial cells, resulting in the acquisition of new genetic traits. E. coli is the most common bacterial species used in the transformation step of a cloning workflow.
In its natural state, the competency of E. coli is very low (10-5−10-10), thus cells must be made competent for efficient transformation. The protocols for preparing competent cells vary by choice of transformation method—heat shock or electroporation. Heat shock transformation is also known as chemical transformation and calcium chloride transformation. This method involves subjecting the cells to a sudden increase in temperature, often achieved by briefly immersing them in hot water or placing them in a heating block, followed by a rapid decrease in temperature through incubation on ice. The heat shock causes the cell membrane to become more permeable, facilitating the uptake of exogenous DNA.
The alternative terms, chemical transformation and calcium chloride transformation, highlight the different methods and reagents that can be used to enhance the efficiency of DNA uptake during the transformation process. In both cases, a starter culture is prepared by inoculating a single fresh colony from an agar plate into a liquid medium. This starter culture and the subsequent sub-cultures are carefully monitored for active growth by continually measuring optical density at 600 nm (OD600). To obtain high transformation efficiency, it is crucial that cell growth is in mid-log phase at the time of harvest—which generally occurs at OD600 between 0.4 and 0.9; the optimal value depends on the culture volume, strain, and protocol. Harvested cells are then processed for heat shock treatment or electroporation.
Transformed E. coli colonies then need to be isolated and expanded to isolate and analyze individual constructs. Depending on the experimental goal, several or several dozen colonies would need to be picked up and expanded. Usually, colonies are picked up by pipette tip and inoculated in <5 mL LB or TB medium with appropriate selective antibiotics for growth to use for small-scale purification (called “miniprep”). If the E. coli strain is growing fast (such as Mach1) then the plasmid can be isolated the same day, otherwise, minipreps are incubated overnight and high-quality plasmids are isolated using commercial miniprep kits.
Finland's Constitution: A New Millennium, New Laws
You may want to see also
Explore related products

Transformation of bacteria with plasmids is important for studies and as a means of storing and replicating plasmids
Transformation is the process by which foreign DNA is introduced into a cell. Transformation of bacteria with plasmids is important for studies in bacteria and as a means of storing and replicating plasmids.
Bacterial transformation is a primary technique in molecular cloning to produce multiple copies of a recombinant DNA molecule. Bacterial transformation is a process in which foreign DNA is introduced into bacterial cells, resulting in the acquisition of new genetic traits. Prior to transformation, recombinant plasmids are constructed by inserting the DNA sequence of interest into a vector as described in traditional cloning basics. In transformation, the DNA, typically in the form of a plasmid, is introduced into a competent strain of bacteria so that the bacteria may then replicate the sequence of interest in amounts suitable for further analysis and/or manipulation.
E. coli is the most common bacterial species used in the transformation step of a cloning workflow. In its natural state, the competency of E. coli is very low, thus cells must be made competent for efficient transformation. The protocols for preparing competent cells vary by choice of transformation method—heat shock or electroporation. Heat shock transformation is also known as chemical transformation and calcium chloride transformation. This method involves subjecting the cells to a sudden increase in temperature, often achieved by briefly immersing them in hot water or placing them in a heating block, followed by a rapid decrease in temperature through incubation on ice. The heat shock causes the cell membrane to become more permeable, facilitating the uptake of exogenous DNA.
Commercial competent cells range significantly in their transformation efficiency. The lowest efficiency cells (usually the least expensive) are fine for transforming plasmid DNA for the purposes of storage and amplification. Higher efficiency cells are more important if you will be transforming with very small amounts of DNA or if you're using multiple plasmids at once. To save money, many labs also make their own competent cells. This is a relatively simple procedure and is useful for performing low-efficiency transformations.
Beyond applications that generate useful products for humans, transformation is incredibly useful in studying genetics. Transformation has enabled scientists to expand their understanding of the functions of specific genes and the regulation of gene expression. A gene of interest (a segment of DNA that codes for a gene to be inserted into a living thing) is commonly inserted into plasmids. Plasmids are small pieces of typically circular, double-stranded DNA that replicate independently of the bacterial chromosome. In recombinant DNA technology, plasmids are often used as vectors—they are used for transferring DNA. Plasmids can be used to carry DNA fragments from one organism to another.
Understanding the Foundation: Key Principles of the Constitution
You may want to see also
Explore related products

Calcium-induced competence is a procedure that involves exposing cells to cations to induce chemical competence
Bacterial transformation is a technique used in molecular cloning to produce multiple copies of recombinant DNA molecules. It involves introducing foreign DNA into bacterial cells, resulting in the acquisition of new genetic traits. E. coli is the most common bacterial species used in the transformation step of a cloning workflow.
E. coli cells in their natural state have very low competency, so they must be made competent for efficient transformation. Calcium-induced competence, also known as the CaCl2 transformation technique, is a procedure that involves exposing cells to cations to induce chemical competence. This method was developed by Mandel and Higa and is based on soaking the cells in cold CaCl2. The calcium cation (Ca2+) has proven to be the most effective in inducing competence, both alone and in combination with other ions.
The CaCl2 transformation technique can be used to create artificial competence, which means they can be made permeable to DNA using unnatural conditions. This is in contrast to natural competence, where bacteria can receive environmental DNA under natural or in vitro conditions. Artificial competence is not encoded in the cell's genes and is a relatively simple and easy procedure that can be used in the genetic engineering of bacteria.
To create artificial competence using the CaCl2 method, small pores are created in bacterial cells by suspending them in a solution containing a high concentration of calcium. This allows DNA to be forced into the host cell through heat shock treatment at 42 degrees Celsius. The heat shock causes the cell membrane to become more permeable, facilitating the uptake of exogenous DNA. The combination of calcium and magnesium has been shown to increase transformation efficiency by 15- to 20-fold compared to cells grown without magnesium.
Overall, calcium-induced competence is a crucial step in the cloning process, allowing for the efficient transformation of E. coli cells and enabling further analysis and manipulation of DNA sequences.
John Adams' Vision: Amendments for the Constitution
You may want to see also
Explore related products

The easiest way to express three genes concurrently is to make an operon and use a single promoter
In genetics, an operon is a functioning unit of DNA that contains a cluster of genes under the control of a single promoter. The genes are transcribed together into an mRNA strand and are either translated together in the cytoplasm or undergo splicing to create monocistronic mRNAs that are translated separately. The result of this is that the genes contained in the operon are either expressed together or not at all. The easiest way to express three genes concurrently is to make an operon and use a single promoter.
Operons are primarily found in prokaryotes but have also been discovered in some eukaryotes, including nematodes such as C. elegans and the fruit fly, Drosophila melanogaster. Operons are defined as a set of adjacent structural genes, plus the adjacent regulatory signals that affect the transcription of the structural genes. The structural genes of an operon are turned on or off together due to a single promoter and operator upstream of them. The promoter is a region of DNA where transcription of a gene is initiated. It controls the binding of RNA polymerase to DNA to initiate the transcription of genes.
The lac operon of the model bacterium Escherichia coli was the first operon to be discovered and provides a typical example of operon function. It consists of three adjacent structural genes, a promoter, a terminator, and an operator. The lac operon is regulated by several factors, including the availability of glucose and lactose. It can be activated by allolactose, which binds to the repressor protein and prevents it from repressing gene transcription.
Bacterial transformation is a process in which foreign DNA is introduced into bacterial cells, resulting in the acquisition of new genetic traits. E. coli is the most common bacterial species used in the transformation step of a cloning workflow. In its natural state, the competency of E. coli is very low, so cells must be made competent for efficient transformation. Transformation of bacteria with plasmids is important not only for studies in bacteria but also because bacteria are used as the means for storing and replicating plasmids.
The President's Powers: Understanding US Constitutional Limits
You may want to see also
Frequently asked questions
Bacterial transformation is a process in which foreign DNA is introduced into bacterial cells, resulting in the acquisition of new genetic traits.
E. coli transformation is an important step that allows the introduction of heterologous DNA using plasmid vectors or introducing mutations via homologous recombination events.
E. coli transformation plays a major role in nature by allowing bacterial cells to exchange genetic material, leading to increased genetic variation and the acquisition of beneficial traits for survival.
The two main methods used for E. coli transformation are chemical transformation and electroporation. Chemical transformation involves treating cells with chemicals like calcium chloride to induce competence and facilitate DNA uptake. Electroporation, on the other hand, uses electric pulses to create pores in the cell membrane for DNA entry.
The choice between constitutive and inducible promoters depends on the specific experiment and expression requirements. If all proteins need to be expressed simultaneously and at a similar ratio, either constitutive or inducible promoters can be used. However, if differential expression is desired, inducible promoters are necessary to independently control the expression of each protein.





























































